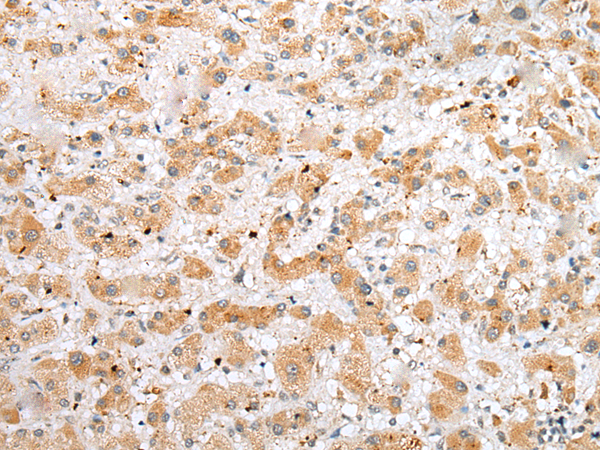

中文名稱: 兔抗NUDT21多克隆抗體
英文名稱: Anti-NUDT21 rabbit polyclonal antibody
別 名: CPSF5; CFIM25
相關(guān)類別: 一抗
抗 原: NUDT21
儲(chǔ) 存: 冷凍(-20℃)
宿 主: Rabbit
反應(yīng)種屬: Human, Mouse, Rat
標(biāo) 記 物: Unconjugate
克隆類型: rabbit polyclonal
技術(shù)規(guī)格
|
Background: |
The protein encoded by this gene is one subunit of a cleavage factor required for 3' RNA cleavage and polyadenylation processing. The interaction of the protein with the RNA is one of the earliest steps in the assembly of the 3' end processing complex and facilitates the recruitment of other processing factors. This gene encodes the 25kD subunit of the protein complex, which is composed of four polypeptides. |
|
Applications: |
ELISA, WB, IHC |
|
Name of antibody: |
NUDT21 |
|
Immunogen: |
Full length fusion protein |
|
Full name: |
nudix (nucleoside diphosphate linked moiety X)-type motif 21 |
|
Synonyms: |
CPSF5; CFIM25 |
|
SwissProt: |
O43809 |
|
ELISA Recommended dilution: |
5000-10000 |
|
IHC positive control: |
Human breast cancer and Human prostate cancer |
|
IHC Recommend dilution: |
20-100 |
|
WB Predicted band size: |
26 kDa |
|
WB Positive control: |
HEPG2 and A172 cell,Human fetal brain tissue,Hela,293T and A431 cell, |
|
WB Recommended dilution: |
200-1000 |

購(gòu)物車
幫助
021-54845833/15800441009
